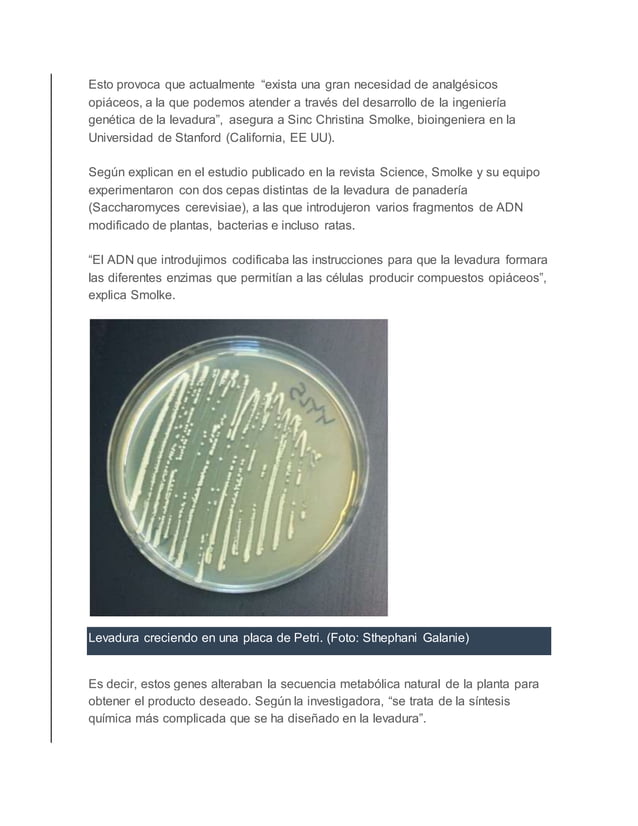
5 avances tecnologicos en la quimica

La Unión Internacional de Química Pura y Aplicada (IUPAC) ha dado a conocer las Diez Principales Tecnologías Emergentes en Química para 2023. El objetivo de esta iniciativa es mostrar el valor transformador de la química e informar al público en general sobre el potencial de las ciencias químicas para fomentar el bienestar de la Sociedad y la sostenibilidad de nuestro planeta.. Research Triangle Park, NC, EE.UU., 17 de octubre de 2023: La Unión Internacional de Química Pura y Aplicada (IUPAC) ha dado a conocer las Diez Principales Tecnologías Emergentes en Química para 2023.

Avances Tecnologicos En La Quimica arbol

QUARK Línea del tiempo del desarrollo de la Química

Últimos 10 avances científicos y tecnológicos Batanga

INNOVACIÓN AL ALCANCE DE TUS MANOS AVANCES TECNOLÓGICOS EN LA QUÍMICA

5 avances tecnologicos en la quimica

Principales tendencias tecnológicas en la industria química

Ciencia 5 avances científicos del 2020 que debes conocer Tips y consejos

Ciencias aplicadas a la actividad profesional 4ºESO Avances y descubrimientos científicos

Nobel de Química 2013 premia las bases de los procesos químicos

Usos de la Tecnología en la Química La Tecnologia Aplicada a la Química

Usos de la Tecnología en la Química La Tecnología en la Química Sector Industrial

La química, la tecnología y tú

Química P1L1 Relación de la Química y la Tecnología YouTube

Avances Cientificos Y Tecnologicos Ejemplos NOSMA

Son Aplicaciones de los Avances Tecnológicos de la Química Ejemplos y Usos de los Avances

5 avances tecnologicos en la quimica

Evolución de la Química LA QUÍMICA EN LA EDAD MODERNA Y CONTEMPORÁNEA

La química, la tecnología y tú

5 avances tecnologicos en la quimica
5 avances tecnologicos en la quimica
La química, como disciplina científica, ha sido la fuerza impulsora detrás de innumerables innovaciones que han transformado nuestra vida cotidiana y moldeado el panorama de diversas industrias. Desde el descubrimiento de nuevos materiales hasta avances en la síntesis de medicamentos, las innovaciones químicas han impactado.. La Unión Internacional de Química Pura y Aplicada (IUPAC) ha publicado las diez mejores tecnologías emergentes en química de 2022. El objetivo de esta iniciativa es mostrar el valor transformador de la química e informar al público en general sobre el potencial de las ciencias químicas para fomentar el bienestar de la sociedad y la sostenibilidad de nuestro planeta.